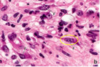

חיבור Flashcards
(57 cards)
מהן שתי ההגדרות לרקמת חיבור?
- קבוצת תאים מגוונת הנמצאת בתוך ECM ספציפי לאותו האיבר.
- המטריקס שנותן תמיכה ומחבר פיזית את הרקמות השונות והתאים השונים בתוך איבר מסויים.
מהו חומר בזופילי?
אוהב בסיס
total preparation מהי?
רקמה דקה שלא צריכה לעבור חיתוך כדי להפוך לסלייד
מה זה מזנטריום?
קרום כפול שמחבר בין הדופן האחורית של חלל הבטן לאיברים בחלל הבטן.
דקה ועשירה בכלי דם.
מהם המרכיבים של רקמת החיבור?
תאים
ECM
ECM ממה מורכב ה?
סיבים (קולגן, אלסטין, סיבים רטיקולריים)
Ground substance-חומרים שאינם סיבים, בעיקר פרוטאוגליקנים וגליקופרוטיאנים
מהם התאים שאפשר למצוא ברקמת החיבור?
1.פיברובלסט- תא מרכזי ברקמת החיבור שמייצר סיבים ומרכיבים של ה
Ground substance
- תאי שומן- אדיפוציטים
- תאי מערכת החיסון- לימפוציטים, פלזמה, מאקרופאגים, תאי מאסט
- תאים נוספים
האם רואים סיבים רטיקולריים בכל צביעה?
לא, למשל ב
H&E לא רואים אותם
מתי הפיברובלסטים עובדים בצורה מוגברת?
שיקום אחרי פצע
איך נראים פיברובלטים במצב רגיל בסליידים?
F מסומנים ב-
צורה של דיסק, לא רואים ציטופלזמה

איך נראה פיברובלסט ברקמה שעוברת שיקום?
F מסומן ב
ניתן לראות ציטופלסמה
מהם תאי מאסט?
תאים שמשחררים היסטמין, אם מופרש יותר מדי היסטמין זה גורם לאלרגיה,
היסטמין מרחיב כלי דם ולכן נצפה לראות את התאים האלו בסמוך לכלי הדם
קשה לראות אותם בסליידים

מהו התא בתמונה?

Plasma cell
מהו התא בתמונה.?

adipose cell
תא שומן
מהו התא בתמונה?

Large lymphocyte
מהו התא בתמונה?

small lymphocyte
מהם התאים בתמונה?

Macrophage

מהו התא בתמונה?

Fibroblast
במה סיבי הקולגן תורמים לרקמת החיבור?
מעניקים לה גמישות וכושר עמידה במתח

איזו רקמת חיבור תהיה בסמוך לרקמת אפיתל?
רקמת חיבור רפה
מה מאפיין רקמת חיבור רפה?
הרבה תאים, מעט סיבים
מה מאפיין רקמת חיבור צפופה?
מעט תאים, הרבה סיבים
איזו רקמת חיבור יש בתמונה?

צפופה אי רגולרית-
הרבה סיבים ומעט תאים
איזו רקמת חיבור יש בתמונה?

רקמת חיבור רפה-
הרבה גרעינים, מעט סיבים




























